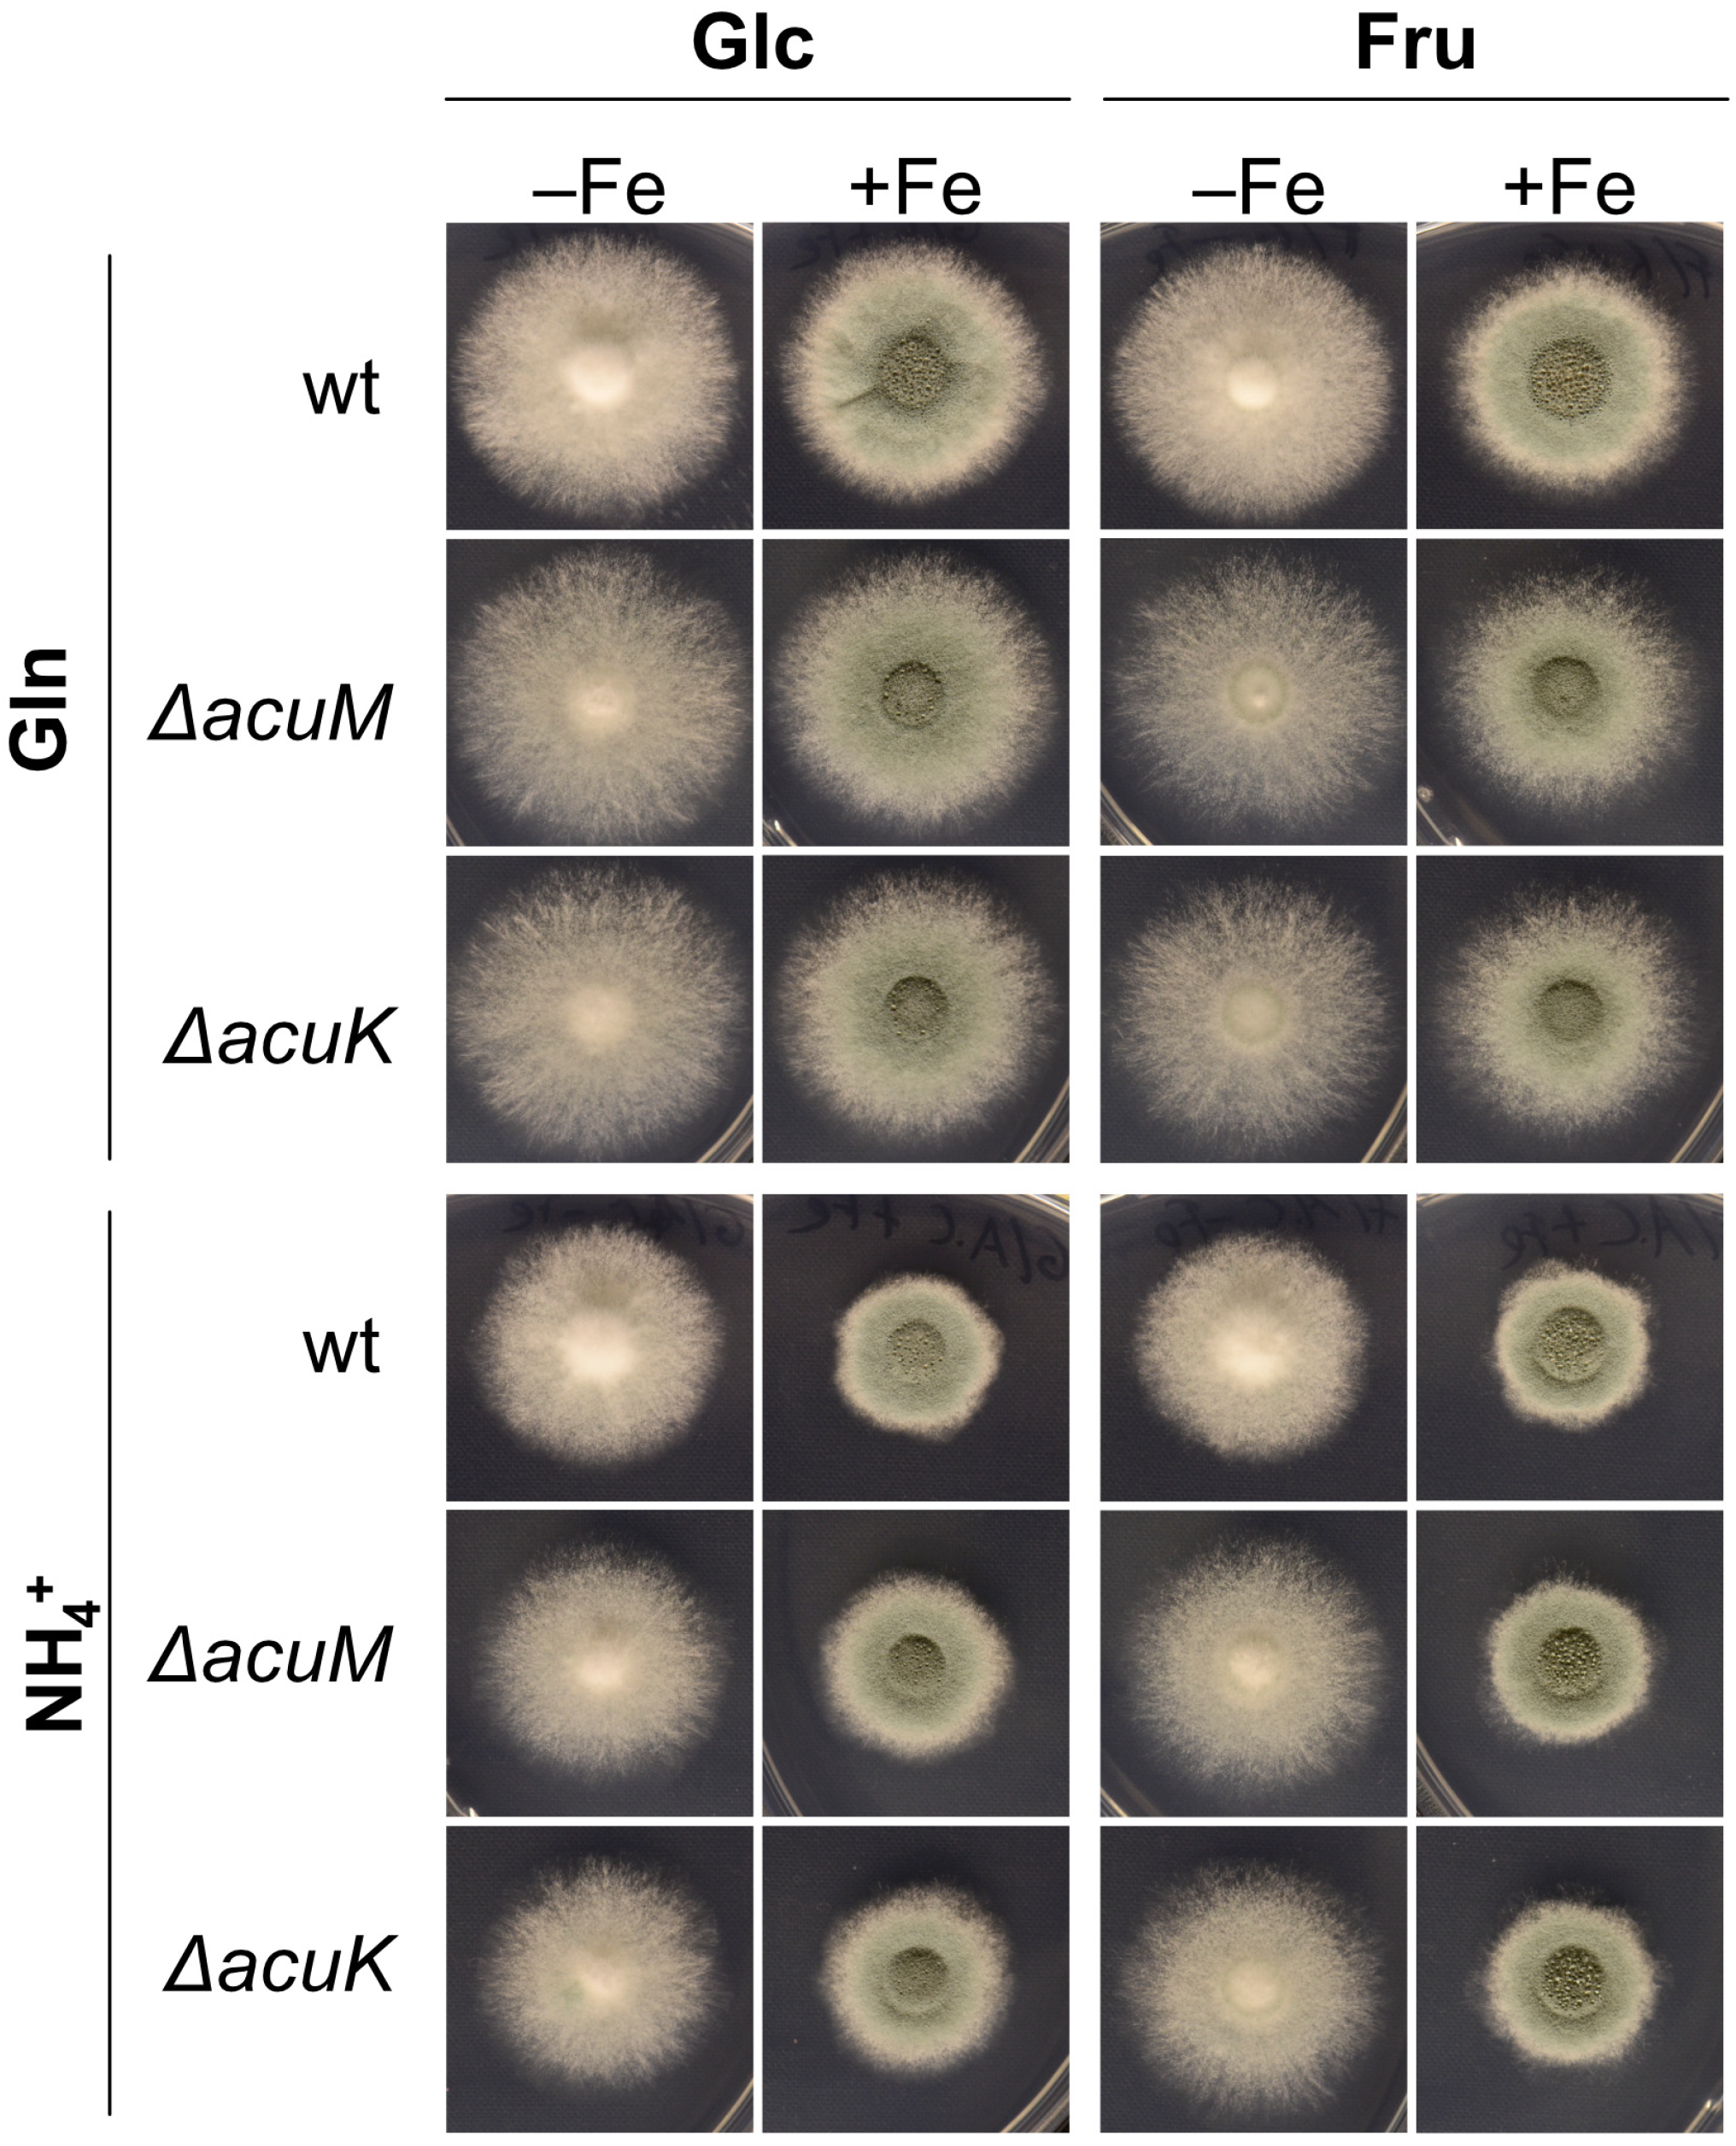
Jof 10 00327 g004
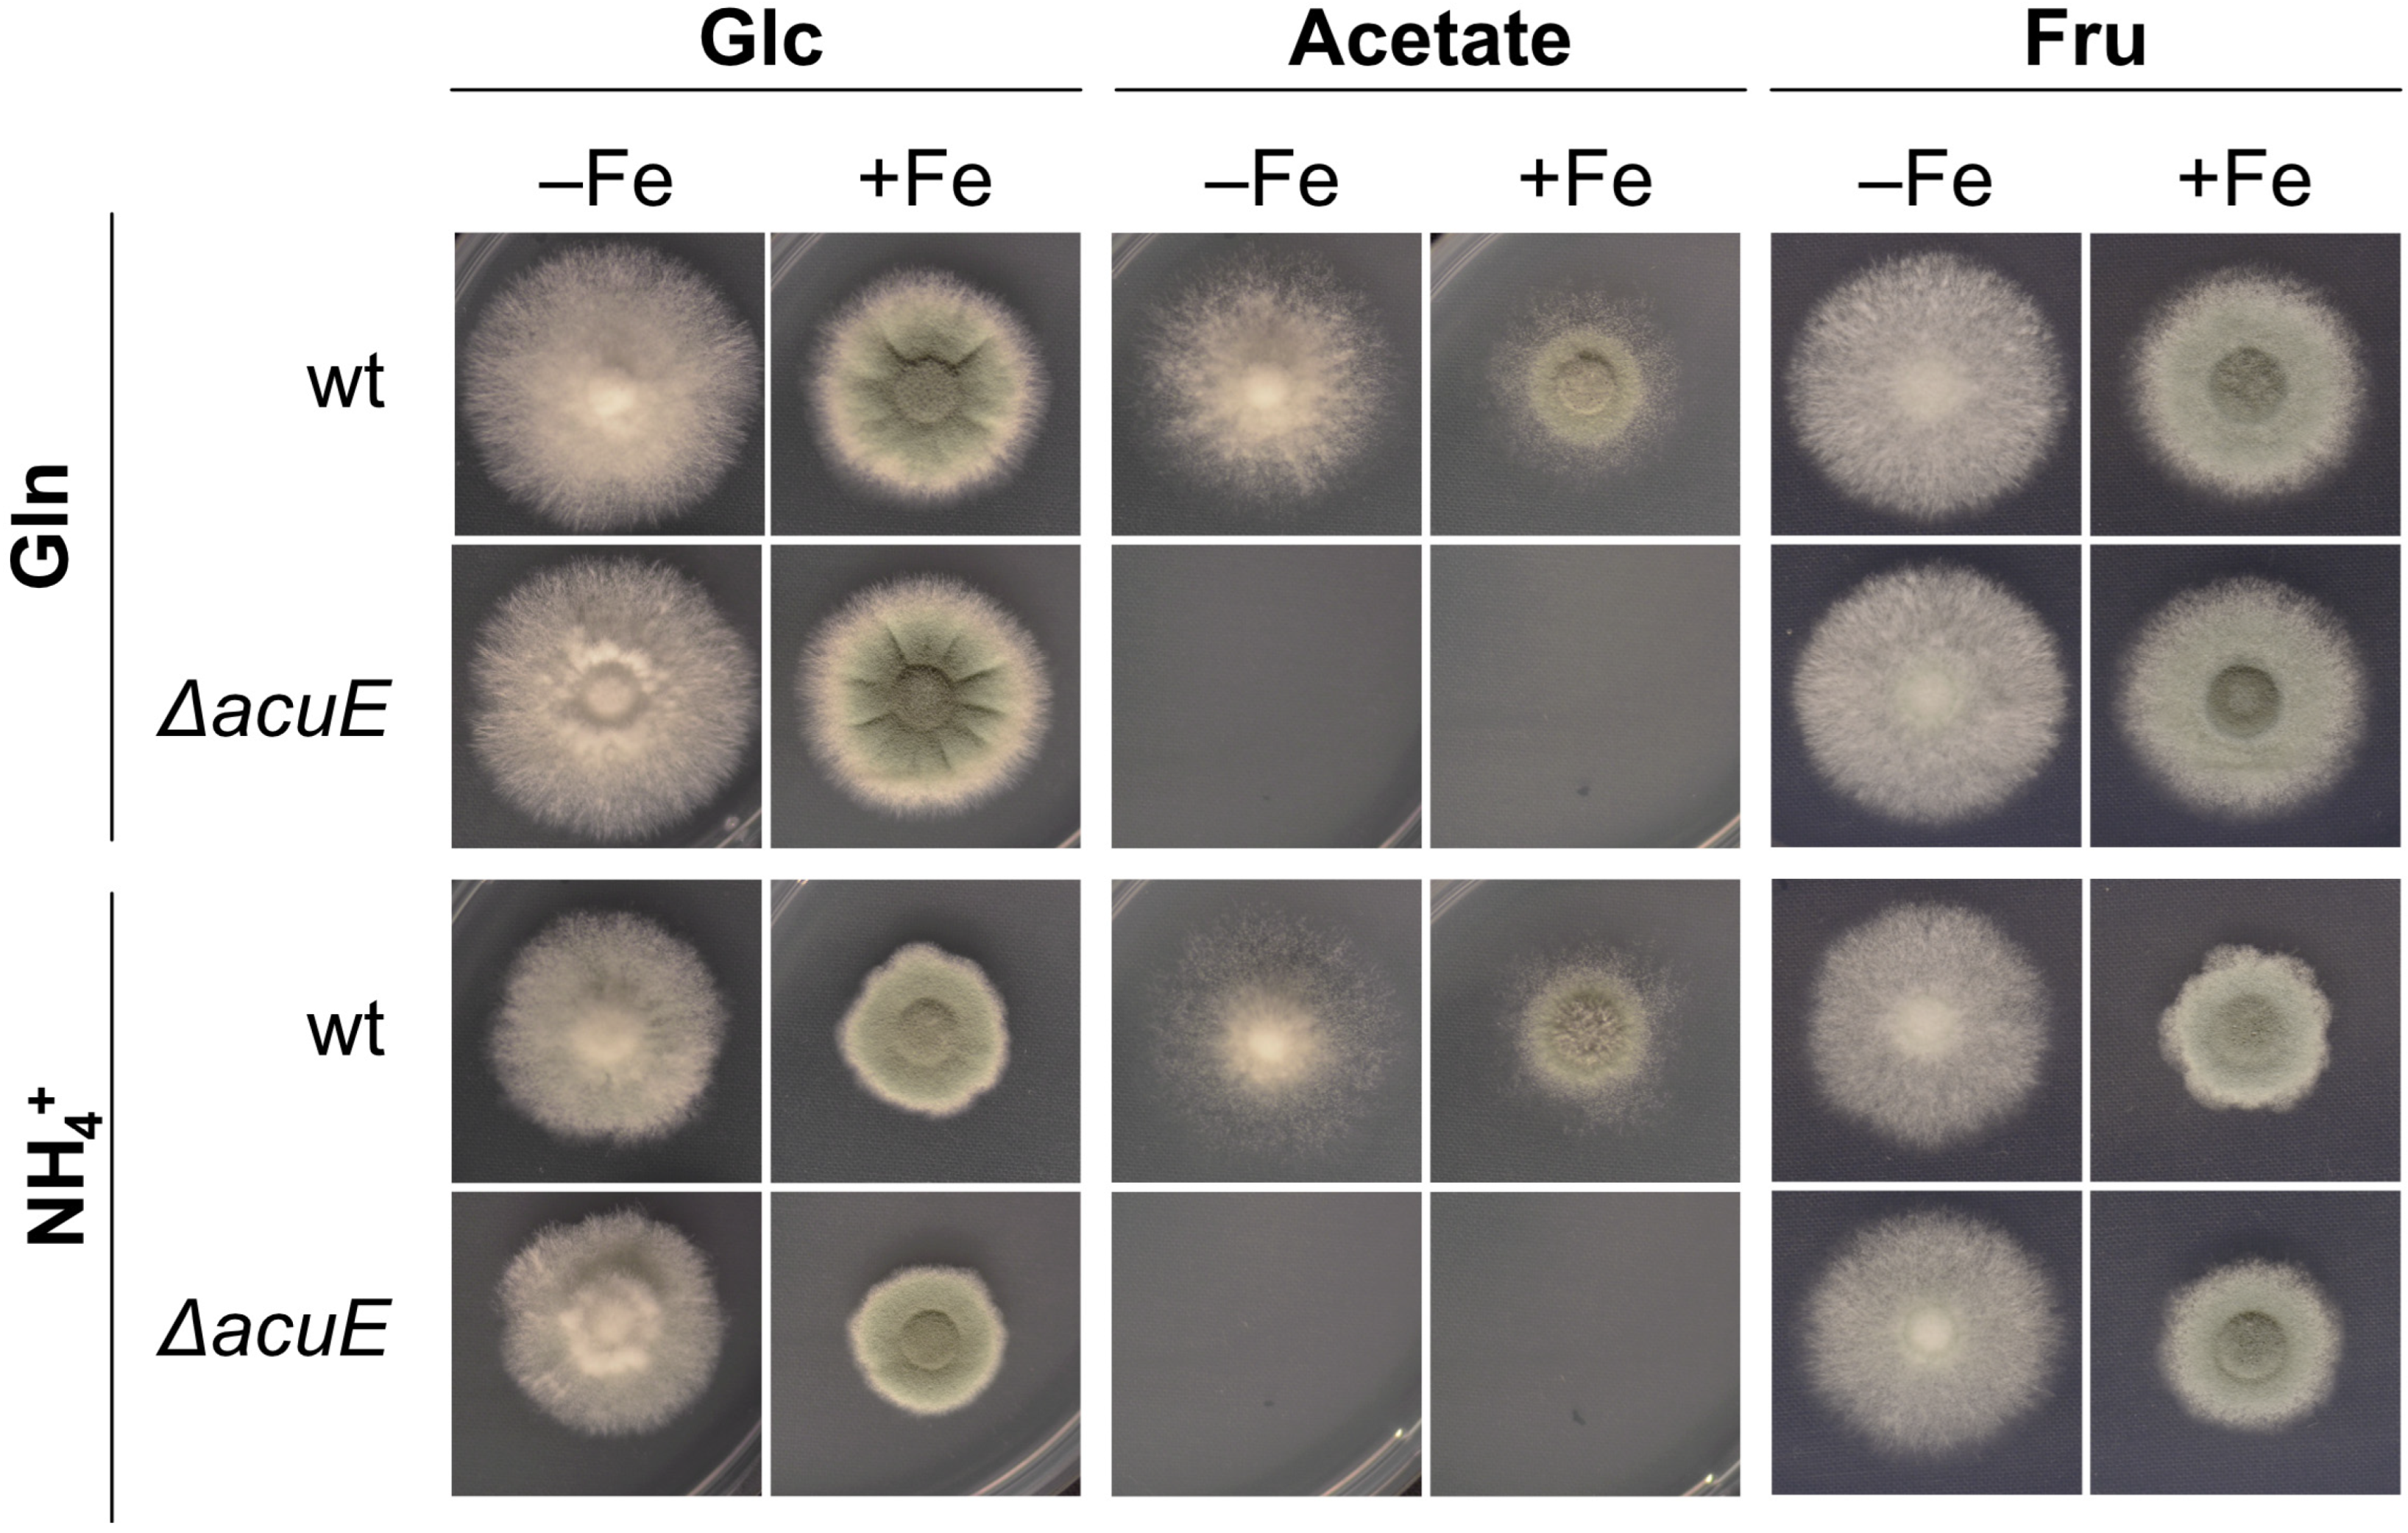
Jof 10 00327 g007

The Transcription Factors AcuK and AcuM Influence Siderophore Biosynthesis of Aspergillus fumigatus
Abstract
1. Introduction
2. Materials and Methods
2.1. Growth Conditions
2.2. A. fumigatus Strains Used
2.3. RNA Isolation and Northern Blot Analysis
2.4. Siderophore Analysis
2.5. Statistical Analysis
3. Results
3.1. Lack of Either AcuM or AcuK Causes a Growth Defect under Both Iron Limitation and Sufficiency
3.2. Lack of Either AcuM or AcuK Decreases the Production of Both Extracellular and Intracellular Siderophores
3.3. Transcriptional Iron Regulation of RIA and SIA Is Largely Unaffected by Lack of AcuK or AcuM
3.4. Acetate Supplementation Cures the Defect in Ferricrocin Production Caused by Lack of AcuM or AcuK
3.5. Transcriptional Regulation of Carbon Metabolism Is Affected by Iron Starvation but Is Only Partly Reliant on AcuM and AcuK
3.6. Lack of AcuE Does Not Affect Growth Nor Siderophore Production
4. Discussion
Supplementary Materials
Author Contributions
Funding
Institutional Review Board Statement
Informed Consent Statement
Data Availability Statement
Conflicts of Interest
References
- Arastehfar, A.; Carvalho, A.; Houbraken, J.; Lombardi, L.; Garcia-Rubio, R.; Jenks, J.D.; Rivero-Menendez, O.; Aljohani, R.; Jacobsen, I.D.; Berman, J.; et al. Aspergillus fumigatus and aspergillosis: From basics to clinics. Stud. Mycol. 2021, 100, 100115. [Google Scholar] [CrossRef]
- Brown, G.D.; Denning, D.W.; Gow, N.A.R.; Levitz, S.M.; Netea, M.G.; White, T.C. Hidden killers: Human fungal infections. Sci. Transl. Med. 2012, 4, 165rv13. [Google Scholar] [CrossRef]
- Misslinger, M.; Hortschansky, P.; Brakhage, A.A.; Haas, H. Fungal iron homeostasis with a focus on Aspergillus fumigatus. Biochim. Biophys. Acta BBA—Mol. Cell Res. 2021, 1868, 118885. [Google Scholar] [CrossRef]
- Blatzer, M.; Binder, U.; Haas, H. The Metalloreductase FreB Is Involved in adaptation of Aspergillus fumigatus to iron starvation. Fungal Genet. Biol. 2011, 48, 1027–1033. [Google Scholar] [CrossRef]
- Schrettl, M.; Bignell, E.; Kragl, C.; Joechl, C.; Rogers, T.; Arst, H.N.; Haynes, K.; Haas, H. Siderophore biosynthesis but not reductive iron assimilation is essential for Aspergillus fumigatus virulence. J. Exp. Med. 2004, 200, 1213–1219. [Google Scholar] [CrossRef]
- Hider, R.C.; Kong, X. Chemistry and biology of siderophores. Nat. Prod. Rep. 2010, 27, 637–657. [Google Scholar] [CrossRef]
- Happacher, I.; Aguiar, M.; Alilou, M.; Abt, B.; Baltussen, T.J.H.; Decristoforo, C.; Melchers, W.J.G.; Haas, H. The siderophore ferricrocin mediates iron acquisition in Aspergillus fumigatus. Microbiol. Spectr. 2023, 11, e00496-23. [Google Scholar] [CrossRef]
- Schrettl, M.; Bignell, E.; Kragl, C.; Sabiha, Y.; Loss, O.; Eisendle, M.; Wallner, A.; Arst, H.N., Jr.; Haynes, K.; Haas, H. Distinct roles for intra- and extracellular siderophores during Aspergillus fumigatus infection. PLoS Pathog. 2007, 3, e128. [Google Scholar] [CrossRef]
- Wallner, A.; Blatzer, M.; Schrettl, M.; Sarg, B.; Lindner, H.; Haas, H. Ferricrocin, a siderophore involved in intra- and transcellular iron distribution in Aspergillus fumigatus. Appl. Environ. Microbiol. 2009, 75, 4194–4196. [Google Scholar] [CrossRef]
- Eisendle, M.; Schrettl, M.; Kragl, C.; Müller, D.; Illmer, P.; Haas, H. The intracellular siderophore ferricrocin is involved in iron storage, oxidative-stress resistance, germination, and sexual development in Aspergillus nidulans. Eukaryot. Cell 2006, 5, 1596–1603. [Google Scholar] [CrossRef]
- Yasmin, S.; Alcazar-Fuoli, L.; Gründlinger, M.; Puempel, T.; Cairns, T.; Blatzer, M.; Lopez, J.F.; Grimalt, J.O.; Bignell, E.; Haas, H. Mevalonate governs interdependency of ergosterol and siderophore biosyntheses in the fungal pathogen Aspergillus fumigatus. Proc. Natl. Acad. Sci. USA 2012, 109, E497–E504. [Google Scholar] [CrossRef]
- Happacher, I.; Aguiar, M.; Yap, A.; Decristoforo, C.; Haas, H. Fungal Siderophore metabolism with a focus on Aspergillus fumigatus: Impact on biotic interactions and potential translational applications. Essays Biochem. 2023, 67, 829–842. [Google Scholar] [CrossRef]
- Blatzer, M.; Schrettl, M.; Sarg, B.; Lindner, H.H.; Pfaller, K.; Haas, H. SidL, an Aspergillus fumigatus transacetylase involved in biosynthesis of the siderophores ferricrocin and hydroxyferricrocin. Appl. Environ. Microbiol. 2011, 77, 4959–4966. [Google Scholar] [CrossRef]
- Aguiar, M.; Orasch, T.; Shadkchan, Y.; Caballero, P.; Pfister, J.; Sastré-Velásquez, L.E.; Gsaller, F.; Decristoforo, C.; Osherov, N.; Haas, H. Uptake of the siderophore triacetylfusarinine C, but not fusarinine C, is crucial for virulence of Aspergillus fumigatus. mBio 2022, 13, e02192-22. [Google Scholar] [CrossRef]
- Aguiar, M.; Orasch, T.; Misslinger, M.; Dietl, A.-M.; Gsaller, F.; Haas, H. The siderophore transporters Sit1 and Sit2 are essential for utilization of ferrichrome-, ferrioxamine- and coprogen-type siderophores in Aspergillus fumigatus. J. Fungi 2021, 7, 768. [Google Scholar] [CrossRef]
- Dietl, A.-M.; Misslinger, M.; Aguiar, M.M.; Ivashov, V.; Teis, D.; Pfister, J.; Decristoforo, C.; Hermann, M.; Sullivan, S.M.; Smith, L.R.; et al. The siderophore transporter Sit1 determines susceptibility to the antifungal VL-2397. Antimicrob. Agents Chemother. 2019, 63, e00807-19. [Google Scholar] [CrossRef]
- Kragl, C.; Schrettl, M.; Abt, B.; Sarg, B.; Lindner, H.H.; Haas, H. EstB-mediated hydrolysis of the siderophore triacetylfusarinine c optimizes iron uptake of Aspergillus fumigatus. Eukaryot. Cell 2007, 6, 1278–1285. [Google Scholar] [CrossRef]
- Gründlinger, M.; Gsaller, F.; Schrettl, M.; Lindner, H.; Haas, H. Aspergillus fumigatus SidJ mediates intracellular siderophore hydrolysis. Appl. Environ. Microbiol. 2013, 79, 7534–7536. [Google Scholar] [CrossRef]
- Ecker, F.; Haas, H.; Groll, M.; Huber, E.M. Iron scavenging in Aspergillus Species: Structural and biochemical insights into fungal siderophore esterases. Angew. Chem. Int. Ed. 2018, 57, 14624–14629. [Google Scholar] [CrossRef]
- Misslinger, M.; Scheven, M.T.; Hortschansky, P.; López-Berges, M.S.; Heiss, K.; Beckmann, N.; Heigl, T.; Hermann, M.; Krüger, T.; Kniemeyer, O.; et al. The monothiol glutaredoxin GrxD is essential for sensing iron starvation in Aspergillus fumigatus. PLoS Genet. 2019, 15, e1008379. [Google Scholar] [CrossRef]
- Misslinger, M.; Lechner, B.E.; Bacher, K.; Haas, H. Iron-sensing is governed by mitochondrial, not by cytosolic iron–sulfur cluster biogenesis in Aspergillus fumigatus. Metallomics 2018, 10, 1687–1700. [Google Scholar] [CrossRef] [PubMed]
- Hortschansky, P.; Haas, H.; Huber, E.M.; Groll, M.; Brakhage, A.A. The CCAAT-binding complex (CBC) in Aspergillus species. Biochim. Biophys. Acta Gene Regul. Mech. 2017, 1860, 560–570. [Google Scholar] [CrossRef] [PubMed]
- Schrettl, M.; Beckmann, N.; Varga, J.; Heinekamp, T.; Jacobsen, I.D.; Jöchl, C.; Moussa, T.A.; Wang, S.; Gsaller, F.; Blatzer, M.; et al. HapX-mediated adaption to iron starvation is crucial for virulence of Aspergillus fumigatus. PLoS Pathog. 2010, 6, e1001124. [Google Scholar] [CrossRef] [PubMed]
- Gsaller, F.; Hortschansky, P.; Beattie, S.R.; Klammer, V.; Tuppatsch, K.; Lechner, B.E.; Rietzschel, N.; Werner, E.R.; Vogan, A.A.; Chung, D.; et al. the Janus transcription factor HapX controls fungal adaptation to both iron starvation and iron excess. EMBO J. 2014, 33, 2261–2276. [Google Scholar] [CrossRef] [PubMed]
- Furukawa, T.; Scheven, M.T.; Misslinger, M.; Zhao, C.; Hoefgen, S.; Gsaller, F.; Lau, J.; Jöchl, C.; Donaldson, I.; Valiante, V.; et al. The fungal CCAAT-Binding complex and HapX display highly variable but evolutionary conserved synergetic promoter-specific DNA recognition. Nucleic Acids Res. 2020, 48, 3567–3590. [Google Scholar] [CrossRef] [PubMed]
- López-Berges, M.S.; Scheven, M.T.; Hortschansky, P.; Misslinger, M.; Baldin, C.; Gsaller, F.; Werner, E.R.; Krüger, T.; Kniemeyer, O.; Weber, J.; et al. The bZIP transcription factor HapX is post-translationally regulated to control iron homeostasis in Aspergillus fumigatus. Int. J. Mol. Sci. 2021, 22, 7739. [Google Scholar] [CrossRef] [PubMed]
- Gsaller, F.; Eisendle, M.; Lechner, B.E.; Schrettl, M.; Lindner, H.; Müller, D.; Geley, S.; Haas, H. The interplay between vacuolar and siderophore-mediated iron storage in Aspergillus fumigatus. Metallomics 2012, 4, 1262–1270. [Google Scholar] [CrossRef] [PubMed]
- Schrettl, M.; Ibrahim-Granet, O.; Droin, S.; Huerre, M.; Latgé, J.-P.; Haas, H. The crucial role of the Aspergillus fumigatus siderophore system in interaction with alveolar macrophages. Microbes Infect. Inst. Pasteur 2010, 12, 1035–1041. [Google Scholar] [CrossRef] [PubMed]
- Chamilos, G.; Bignell, E.M.; Schrettl, M.; Lewis, R.E.; Leventakos, K.; May, G.S.; Haas, H.; Kontoyiannis, D.P. Exploring the concordance of Aspergillus fumigatus pathogenicity in mice and Toll-deficient flies. Med. Mycol. 2010, 48, 506–510. [Google Scholar] [CrossRef] [PubMed]
- Slater, J.L.; Gregson, L.; Denning, D.W.; Warn, P.A. Pathogenicity of Aspergillus fumigatus mutants assessed in Galleria mellonella matches that in mice. Med. Mycol. 2011, 49, S107–S113. [Google Scholar] [CrossRef]
- Long, N.; Orasch, T.; Zhang, S.; Gao, L.; Xu, X.; Hortschansky, P.; Ye, J.; Zhang, F.; Xu, K.; Gsaller, F.; et al. The Zn2Cys6-type transcription factor LeuB cross-links regulation of leucine biosynthesis and iron acquisition in Aspergillus fumigatus. PLoS Genet. 2018, 14, e1007762. [Google Scholar] [CrossRef] [PubMed]
- Yap, A.; Volz, R.; Paul, S.; Moye-Rowley, W.S.; Haas, H. Regulation of high-affinity iron acquisition, including acquisition mediated by the iron permease FtrA, is coordinated by AtrR, SrbA, and SreA in Aspergillus fumigatus. mBio 2023, 14, e00757-23. [Google Scholar] [CrossRef]
- Pongpom, M.; Liu, H.; Xu, W.; Snarr, B.D.; Sheppard, D.C.; Mitchell, A.P.; Filler, S.G. Divergent targets of Aspergillus fumigatus AcuK and AcuM transcription factors during growth in vitro versus invasive disease. Infect. Immun. 2015, 83, 923–933. [Google Scholar] [CrossRef] [PubMed]
- Suzuki, Y.; Murray, S.L.; Wong, K.H.; Davis, M.A.; Hynes, M.J. Reprogramming of carbon metabolism by the transcriptional activators AcuK and AcuM in Aspergillus nidulans. Mol. Microbiol. 2012, 84, 942–964. [Google Scholar] [CrossRef] [PubMed]
- Hynes, M.J.; Szewczyk, E.; Murray, S.L.; Suzuki, Y.; Davis, M.A.; Sealy-Lewis, H.M. Transcriptional control of gluconeogenesis in Aspergillus nidulans. Genetics 2007, 176, 139–150. [Google Scholar] [CrossRef] [PubMed]
- Liu, H.; Gravelat, F.N.; Chiang, L.Y.; Chen, D.; Vanier, G.; Ejzykowicz, D.E.; Ibrahim, A.S.; Nierman, W.C.; Sheppard, D.C.; Filler, S.G. Aspergillus fumigatus AcuM regulates both iron acquisition and gluconeogenesis. Mol. Microbiol. 2010, 78, 1038–1054. [Google Scholar] [CrossRef] [PubMed][Green Version]
- Pontecorvo, G.; Roper, J.A.; Hemmons, L.M.; Macdonald, K.D.; Bufton, A.W.J. The genetics of Aspergillus nidulans. Adv. Genet. 1953, 5, 141–238. [Google Scholar] [CrossRef] [PubMed]
- Furukawa, T.; van Rhijn, N.; Fraczek, M.; Gsaller, F.; Davies, E.; Carr, P.; Gago, S.; Fortune-Grant, R.; Rahman, S.; Gilsenan, J.M.; et al. The Negative Cofactor 2 complex is a key regulator of drug resistance in Aspergillus fumigatus. Nat. Commun. 2020, 11, 427. [Google Scholar] [CrossRef] [PubMed]
- Fraczek, M.G.; Bromley, M.; Buied, A.; Moore, C.B.; Rajendran, R.; Rautemaa, R.; Ramage, G.; Denning, D.W.; Bowyer, P. The Cdr1B efflux transporter is associated with non-Cyp51a-mediated itraconazole resistance in Aspergillus fumigatus. J. Antimicrob. Chemother. 2013, 68, 1486–1496. [Google Scholar] [CrossRef]
- Bertuzzi, M.; van Rhijn, N.; Krappmann, S.; Bowyer, P.; Bromley, M.J.; Bignell, E.M. On the lineage of Aspergillus fumigatus isolates in common laboratory use. Med. Mycol. 2020, 59, 7–13. [Google Scholar] [CrossRef] [PubMed]
- da Silva Ferreira, M.E.; Kress, M.R.V.Z.; Savoldi, M.; Goldman, M.H.S.; Härtl, A.; Heinekamp, T.; Brakhage, A.A.; Goldman, G.H. The AkuBKU80 mutant deficient for nonhomologous end joining is a powerful tool for analyzing pathogenicity in Aspergillus fumigatus. Eukaryot. Cell 2006, 5, 207–211. [Google Scholar] [CrossRef]
- Punt, P.J.; Oliver, R.P.; Dingemanse, M.A.; Pouwels, P.H.; van den Hondel, C.A.M.J.J. Transformation of Aspergillus based on the hygromycin B resistance marker from Escherichia coli. Gene 1987, 56, 117–124. [Google Scholar] [CrossRef]
- Tilburn, J.; Scazzocchio, C.; Taylor, G.G.; Zabicky-Zissman, J.H.; Lockington, R.A.; Davies, R.W. Transformation by integration in Aspergillus nidulans. Gene 1983, 26, 205–221. [Google Scholar] [CrossRef] [PubMed]
- Szewczyk, E.; Nayak, T.; Oakley, C.E.; Edgerton, H.; Xiong, Y.; Taheri-Talesh, N.; Osmani, S.A.; Oakley, B.R. Fusion PCR and gene targeting in Aspergillus nidulans. Nat. Protoc. 2006, 1, 3111–3120. [Google Scholar] [CrossRef] [PubMed]
- Adnan, M.; Zheng, W.; Islam, W.; Arif, M.; Abubakar, Y.S.; Wang, Z.; Lu, G. Carbon catabolite repression in filamentous fungi. Int. J. Mol. Sci. 2017, 19, 48. [Google Scholar] [CrossRef] [PubMed]
- Olivas, I.; Royuela, M.; Romero, B.; Monteiro, M.C.; Mínguez, J.M.; Laborda, F.; De Lucas, J.R. Ability to grow on lipids accounts for the fully virulent phenotype in neutropenic mice of Aspergillus fumigatus null mutants in the key glyoxylate cycle enzymes. Fungal Genet. Biol. FG B 2008, 45, 45–60. [Google Scholar] [CrossRef] [PubMed]
- Todd, R.B.; Andrianopoulos, A.; Davis, M.A.; Hynes, M.J. FacB, the Aspergillus nidulans activator of acetate utilization genes, binds dissimilar DNA sequences. EMBO J. 1998, 17, 2042–2054. [Google Scholar] [CrossRef] [PubMed]
- Hynes, M.J.; Murray, S.L. ATP-citrate lyase is required for production of cytosolic acetyl coenzyme a and development in Aspergillus nidulans. Eukaryot. Cell 2010, 9, 1039–1048. [Google Scholar] [CrossRef] [PubMed]
- Schrettl, M.; Kim, H.S.; Eisendle, M.; Kragl, C.; Nierman, W.C.; Heinekamp, T.; Werner, E.R.; Jacobsen, I.; Illmer, P.; Yi, H.; et al. SreA-Mediated Iron Regulation in Aspergillus Fumigatus. Mol. Microbiol. 2008, 70, 27–43. [Google Scholar] [CrossRef] [PubMed]
- Sandeman, R.A.; Hynes, M.J. Isolation of the FacA (acetyl-coenzyme a synthetase) and AcuE (malate synthase) genes of Aspergillus nidulans. Mol. Gen. Genet. MGG 1989, 218, 87–92. [Google Scholar] [CrossRef] [PubMed]
- Gründlinger, M.; Yasmin, S.; Lechner, B.E.; Geley, S.; Schrettl, M.; Hynes, M.; Haas, H. Fungal siderophore biosynthesis is partially localized in peroxisomes. Mol. Microbiol. 2013, 88, 862–875. [Google Scholar] [CrossRef]
- Iacovelli, R.; Bovenberg, R.A.L.; Driessen, A.J.M. Nonribosomal Peptide Synthetases and Their Biotechnological Potential in Penicillium rubens. J. Ind. Microbiol. Biotechnol. 2021, 48, kuab045. [Google Scholar] [CrossRef] [PubMed]
- Kishi-Kaboshi, M.; Okada, K.; Kurimoto, L.; Murakami, S.; Umezawa, T.; Shibuya, N.; Yamane, H.; Miyao, A.; Takatsuji, H.; Takahashi, A.; et al. A Rice Fungal MAMP-Responsive MAPK Cascade Regulates Metabolic Flow to Antimicrobial Metabolite Synthesis. Plant J. 2010, 63, 599–612. [Google Scholar] [CrossRef]
- Bauer, I.; Abt, B.; Yap, A.; Leuchtle, B.; Haas, H. Online biomass monitoring enables characterization of the growth pattern of Aspergillus fumigatus in liquid shake conditions. J. Fungi 2022, 8, 1013. [Google Scholar] [CrossRef] [PubMed]
- Sigman, D.S.; Landgraf, R.; Perrin, D.M.; Pearson, L. Nucleic acid chemistry of the cuprous complexes of 1,10-phenanthroline and derivatives. Met. Ions Biol. Syst. 1996, 33, 485–513. [Google Scholar]
- Nam, K.H. Structural analysis of metal chelation of the metalloproteinase thermolysin by 1,10-phenanthroline. J. Inorg. Biochem. 2021, 215, 111319. [Google Scholar] [CrossRef] [PubMed]

Disclaimer/Publisher’s Note: The statements, opinions and data contained in all publications are solely those of the individual author(s) and contributor(s) and not of MDPI and/or the editor(s). MDPI and/or the editor(s) disclaim responsibility for any injury to people or property resulting from any ideas, methods, instructions or products referred to in the content. |
© 2024 by the authors. Licensee MDPI, Basel, Switzerland. This article is an open access article distributed under the terms and conditions of the Creative Commons Attribution (CC BY) license (https://creativecommons.org/licenses/by/4.0/).
Share and Cite
Caballero, P.; Yap, A.; Bromley, M.J.; Haas, H. The Transcription Factors AcuK and AcuM Influence Siderophore Biosynthesis of Aspergillus fumigatus. J. Fungi 2024, 10, 327. https://doi.org/10.3390/jof10050327
Caballero P, Yap A, Bromley MJ, Haas H. The Transcription Factors AcuK and AcuM Influence Siderophore Biosynthesis of Aspergillus fumigatus. Journal of Fungi. 2024; 10(5):327. https://doi.org/10.3390/jof10050327
Chicago/Turabian StyleCaballero, Patricia, Annie Yap, Michael J. Bromley, and Hubertus Haas. 2024. "The Transcription Factors AcuK and AcuM Influence Siderophore Biosynthesis of Aspergillus fumigatus" Journal of Fungi 10, no. 5: 327. https://doi.org/10.3390/jof10050327
APA StyleCaballero, P., Yap, A., Bromley, M. J., & Haas, H. (2024). The Transcription Factors AcuK and AcuM Influence Siderophore Biosynthesis of Aspergillus fumigatus. Journal of Fungi, 10(5), 327. https://doi.org/10.3390/jof10050327

